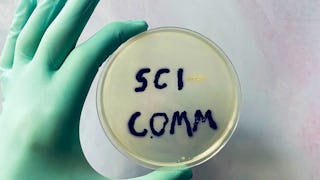

In a world of information overload, how does one find reliable information? Science is supposed to be the answer to our society's complicated challenges. However, as the Covid-19 pandemic highlighted, not understanding what is fake news, misinformation or what is fact may lead to widespread public mistrust, or turn science into fuel for conspiracy theories or propaganda. Scientific findings are prone to change, making it difficult to effectively communicate them to the public. This fosters broad public skepticism towards major institutions, from the government to media to science. So, how can we communicate science effectively? And how can we rebuild trust in science? As a result, it is critical that we reconsider our science communication practices to recover public trust.

Science Communication: Communicating Trustworthy Information in the Digital World
Ends soon! Get one of our best deals with Coursera Plus for $199 (usually $399). Save now.

Science Communication: Communicating Trustworthy Information in the Digital World


Instructors: Jason H. Pridmore
3,959 already enrolled
Included with
61 reviews
What you'll learn
Learn about the best practices for effective science communication
Understand how different stakeholders (policymakers, scientists, journalists) approach science communication
Learn about the advantages and drawbacks of communicating science in digital media and their implications for public trust.
Develop hands-on skills using tools and resources to evaluate information in digital media.
Details to know

Add to your LinkedIn profile
4 assignments
See how employees at top companies are mastering in-demand skills

There are 8 modules in this course
Instructors


Offered by
Explore more from Governance and Society
Status: Preview
Status: PreviewUniversity of Colorado Boulder
 Status: Free Trial
Status: Free TrialUniversity of Colorado Boulder
 Status: Free Trial
Status: Free TrialUniversity of Colorado Boulder
 Status: Free
Status: FreeUniversity of Alberta
Why people choose Coursera for their career

Felipe M.

Jennifer J.

Larry W.

Chaitanya A.
Learner reviews
- 5 stars
63.93%
- 4 stars
29.50%
- 3 stars
4.91%
- 2 stars
1.63%
- 1 star
0%
Showing 3 of 61
Reviewed on Mar 19, 2024
Great course important to every communicator and scientist
Reviewed on Aug 10, 2024
In my view, this is very good course for anyone who wants to learn communicating science to the citizens. This course will serve you as a launching pad in the field of science communication.
Reviewed on May 16, 2024
I learned new things, clear, concise, and effective!




